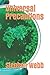
Universal Precautions

Universal Precautions > Editions
by Stephen Webb
Published June 20th 2020
by Independently published
Paperback, 171 pages
Published June 19th 2020
Kindle Edition, 173 pages